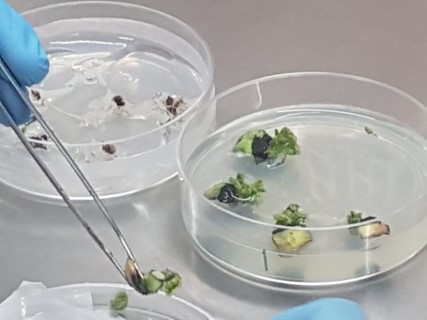

A necessidade crescente de sementes de alta qualidade sanitária vai nortear as discussões do 16º Simpósio Brasileiro de Patologia de Sementes, que vai ocorrer, dia 11 de setembro, durante o XXII Congresso Brasileiro de Sementes, de 10 a 13 de setembro de 2024, em Foz do Iguaçu (PR). O objetivo do simpósio é discutir as lacunas e problemas relacionados à sanidade de sementes, trazendo especialistas de diversos setores para buscar soluções práticas e eficazes.
O simpósio contará com uma ampla programação, incluindo sessões de palestras, uma mesa redonda e o lançamento do livro “Patologia de Sementes: a Ciência Básica”, escrito por mais de 50 autores especialistas em áreas relevantes para a sanidade de sementes.
A coordenadora do Comitê de Patologia de Sementes, Ellen Noly Barrocas, explica que no Congresso anterior foram identificados os principais gargalos visando a melhoria da sanidade de sementes brasileira, incluindo a falta de treinamento, a carência de laboratórios especializados e a diminuição profissionais com especialização na área. “Este simpósio visa não apenas discutir esses problemas, mas também propor soluções e iniciar em um futuro bem próximo programas de treinamento para atender a essas demandas”, afirma Ellen.
A mesa redonda será o ponto central das discussões, abordando os problemas mais urgentes na sanidade de sementes, com foco nas soluções práticas. “Contaremos com a participação de diversos especialistas e representantes de diversas áreas, que vão trazer a perspectiva dos desafios enfrentados neste setor e soluções que o setor vem desenvolvendo”, explica Ellen, que estará na coordenação da mesa redonda.
A especialista em qualidade de sementes, Maria de Fátima Zorato, da MF Zorato Treinamentos (PR), é uma das convidadas para a mesa redonda e vai falar sobre o impacto da utilização de sementes de qualidade fitossanitária e as necessidades dos produtores.
Também participará da mesa redonda a pesquisadora e professora Norimar Denardin, da Universidade de Passo Fundo e do Centro de Biotecnologia na Agricultura (Cebtecagro), que fará uma análise crítica das práticas laboratoriais de avaliação de qualidade de sementes e a adequação da legislação atual.
Também foi convidada Evelyn Koch, vice-coordenadora do comitê, especialista em Controle de Qualidade e Sistemas de Gestão da Qualidade em Laboratórios, da consultoria Conqualy, que irá ressaltar a importância da qualidade dos laboratórios, padronização de métodos e a necessidade de treinamento em sanidade de sementes.
A Coordenadora do Laboratório Agronômica – Diagnóstico Fitossanitário e Consultoria, Tatiana Mituti, vai trazer para o debate uma visão prática sobre a gestão dos principais problemas na sanidade de sementes, tanto no mercado nacional quanto internacional.
Complementando a mesa redonda, o representante do Ministério da Agricultura e Pecuária (MAPA), coordenador de Controle de Pragas, Glauco Antonio Teixeira, que vai abordar a legislação pertinente à sanidade de sementes e discutir legislações atuais relacionadas ao tema.
Para falar sobre o ensino da patologia de sementes nas universidades e os desafios na formação acadêmica foi convidado o professor José da Cruz Machado, professor voluntário da Universidade Federal de Lavras
E para fechar o assunto, teremos a participação de Fernanda Falcão, da Sementes Falcão, que trará a visão dos produtores sobre a necessidade de garantia de sanidade para as sementes que vão ao campo.
Palestras
Além da mesa redonda, o simpósio terá palestras sobre temas essenciais, incluindo o cenário atual da análise sanitária de sementes, que será proferida pela professora Carolina Siqueira, da Universidade Federal de Lavras (MG).
O representante da Tagro -Tecnologia Agropecuária, Carlos Utiamada, vai apresentar em sua palestra os resultados do ensaio de rede de tratamento de sementes e a gerente de Estratégias de Regulamentação de Sementes- Bayer LATAM, Maria Arminda, vai falar sobre as estratégias da indústria frente a regulamentação e Sanidade.
Para fechar o ciclo de palestras, o gerente da Kynetec, Cristiano Limberger, vai abordar a evolução do mercado de tratamento de sementes no controle de doenças.
Desafios e caminhos para o futuro
A coordenadora do Comitê de Patologia de Sementes, Ellen Noly Barrocas, observa que a detecção precoce e o manejo adequado de patógenos em sementes são fundamentais para a sustentabilidade da produção agrícola e para a segurança alimentar global.
Ela destaca a importância de métodos de diagnóstico eficientes para detectar microrganismos patogênicos em sementes que podem comprometer os cultivos agrícolas. “Técnicas avançadas, como as moleculares, são essenciais para identificar patógenos com precisão e rapidez, prevenindo a disseminação de doenças e garantindo a qualidade das sementes”, afirma a especialista.